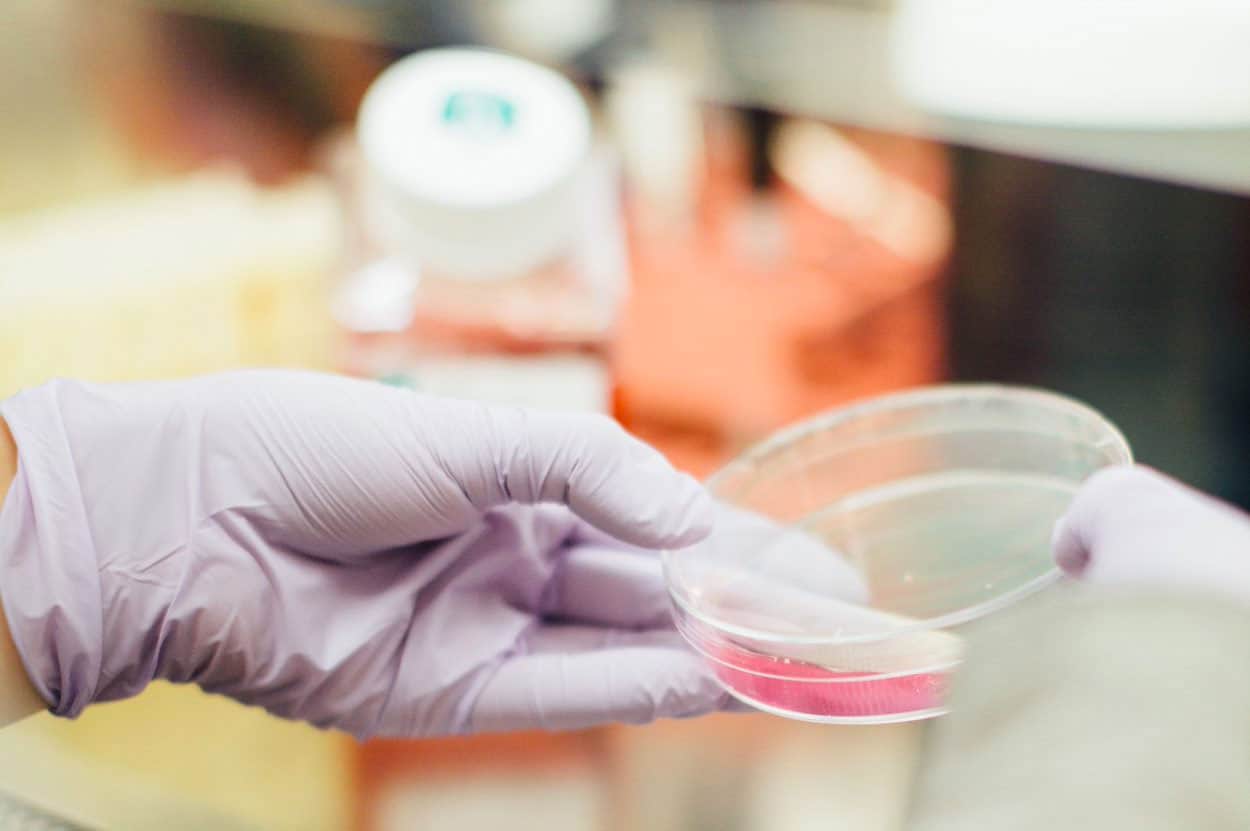

CanHOPE adalah layanan dukungan dan konseling kanker nirlaba yang disediakan oleh Parkway Cancer Centre, Singapura.

TENTANG KANKER
Apakah Kanker itu?
Ketika bahan genetik (DNA) sel rusak atau berubah sehingga menghasilkan mutasi yang mempengaruhi pertumbuhan dan pembelahan sel normal. Ketika ini terjadi, sel-sel tidak mati pada saat yang seharusnya dan sel-sel baru terbentuk ketika tubuh tidak membutuhkannya. Sel ekstra dapat membentuk massa jaringan yang disebut tumor. Ketika tumor ini berkembang menjadi ganas, mereka tumbuh menjadi kanker dan dapat menyebar ke bagian tubuh lainnya.
Fakta-fakta kunci

9,6 juta orang di seluruh dunia diperkirakan meninggal akibat kanker pada 2018

1 dari 6 kematian disebabkan oleh kanker

Kanker yang paling umum adalah Paru-Paru, Payudara, Kolorektal, Prostat, Kanker Kulit (non-melanoma) dan Perut.
Apa Penyebab Kanker?
“Kanker muncul dari transformasi sel normal menjadi sel tumor dalam berbagai tahapan proses yang umumnya berkembang dari lesi pra-kanker menjadi tumor ganas. Perubahan ini merupakan hasil interaksi antara faktor genetik seseorang dan 3 kategori agen eksternal, termasuk:

Karsinogen fisik, seperti ultraviolet dan radiasi pengion

Karsinogen kimiawi, seperti asbes, komponen asap tembakau, aflatoksin (kontaminasi pada makanan), dan arsen (kontaminasi pada air minum)

Karsinogen biologis, seperti infeksi dari virus, bakteri, atau parasit tertentu.
Penuaan adalah faktor fundamental lain dalam perkembangan kanker. Insiden kanker meningkat secara dramatis seiring bertambahnya usia, hal ini kemungkinan besar dikarenakan peningkatan risiko untuk kanker tertentu yang meningkat seiring bertambahnya usia. Akumulasi risiko keseluruhan dikombinasikan dengan kecenderungan mekanisme perbaikan sel menjadi kurang efektif seiring bertambahnya usia seseorang.
Faktor risiko

Konsumsi tembakau, konsumsi alkohol, pola makan yang tidak sehat, dan kurangnya aktivitas fisik adalah faktor risiko utama kanker di seluruh dunia

Virus hepatitis B dan C serta beberapa jenis HPV masing-masing meningkatkan risiko kanker hati dan serviks

Mengubah atau menghindari faktor risiko utama dapat mengurangi kemungkinan kanker secara signifikan
Skrining dan Pencegahan

30-50% kanker dapat dicegah dengan pilihan gaya hidup sehat

Deteksi dan pengobatan kanker dini dapat mengurangi kematian akibat kanker
Beberapa jenis kanker yang paling umum, seperti kanker payudara, kanker serviks, kanker mulut, dan kanker kolorektal memiliki tingkat kesembuhan yang tinggi bila terdeteksi sejak dini dan ditangani sesuai dengan praktik terbaik

